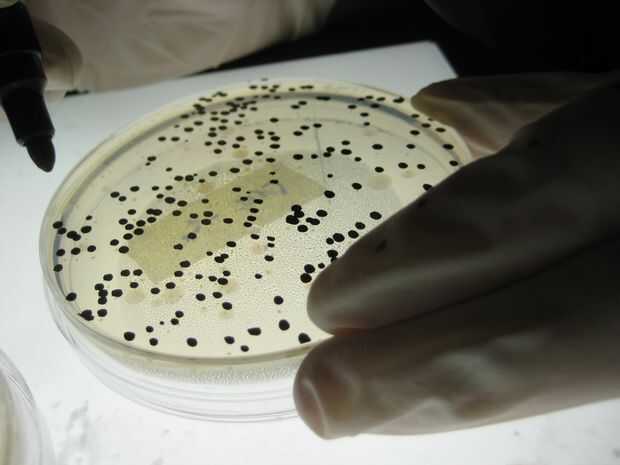

Showerloop es un sistema de filtración y purificación de agua que recicla el agua de la ducha en tiempo real lo que le permite ducharse con agua caliente durante mucho tiempo pero sólo utilizar 10 litros de agua por ducha (ducha normal = ~6-10l/min) y una fracción de la energía (alrededor de una décima parte) en comparación con una ducha normal. El dispositivo puede instalarse dentro o fuera de una ducha o bañera. Los componentes principales son una bomba, arena y filtros de carbón activado y una lámpara UV. El sistema pesa unos 20kg y está hecho de acrílico transparente, acero o plástico tubos conectores y tubería de cobre, de plástico o de goma.
El costo total de la versión más sencilla me ha costado unos 600€ (~ $655 USD) dependiendo de la disponibilidad y precios de materiales de la zona y los componentes utilizados.
Los filtros pueden durar como mucho tiempo como dos años (pero más como 1 año) con todos los días pero depende del comportamiento y la suciedad general del usuario/s. Se puede lavar el filtro de arena, el carbón activado o la CA puede regenerar pero sólo a altas temperaturas > 500 grados C o compostado y la lámpara UV debería durar miles de horas, pero puede ser reciclada y substituida como cualquier otra CFL.
La estructura básica de Showerloop es increíblemente modular en términos de colocación, selección de materiales y estética. Las limitaciones sólo provienen de las dimensiones del filtro ideal y la potencia de la lámpara de UV que se exploran en la tesis de grado ShowerMagic: A higiene y Eco-eficientes en tiempo Real volver sistema de aguas grises de duchas aquí: https://www.theseus.fi/handle/10024/76148
Si usted va a construir, construido o fabricación de Showerloop o algo basado en este documento por favor nos ayudan a seguir trabajando en él donando nos, compra el KIT o piezas o de lo contrario trabajar con nosotros. Sin su apoyo trabajamos a nuestras colillas para ayudar a salvar el mundo!

Porque el agua siempre debe ser limpia 100% o lo más cerca posible la tabla NTU reducción (%) por encima debe consultarse si usando diferentes dimensiones para el filtro. Significa NTU unidades de turbidez nefelométricas. Es una unidad de medida para la cantidad de partículas flotantes en el agua. El agua potable tiene un valor bajo de 10 NTU, generalmente alrededor de 4 y agua visiblemente contaminada tiene una NTU sobre 15-20. NTU se mide ópticamente o químicamente. Tenemos algunas ideas de diseño para un sensor de código abierto, o varios y quisiera algunos haciéndolos.
Aunque técnicamente una lámpara de Ultravioleta de 10W puede ser suficiente para la eliminación de e. coli que se utiliza como un indicador de calidad de agua, otras bacterias y virus son mucho más potentes y así elegimos utilizar concentraciones muy altas de luz ultravioleta para crear un búfer de seguridad. Según nuestra investigación la lámpara potente es más que suficiente en la eliminación de bacterias incluso cuando los filtros fallan que significa que incluso si el agua se ve, se siente o gustos divertido no debería haber efectos adversos para la salud debido a la acción microbiana. Si lo hace sin embargo, es tiempo para verificar, conservar o reemplazar los filtros. Usar múltiples lámparas UV puede ser una buena manera de tanto aseguran que el agua es siempre libres de bacterias y todo exceso de calor va a mantener la temperatura del agua.